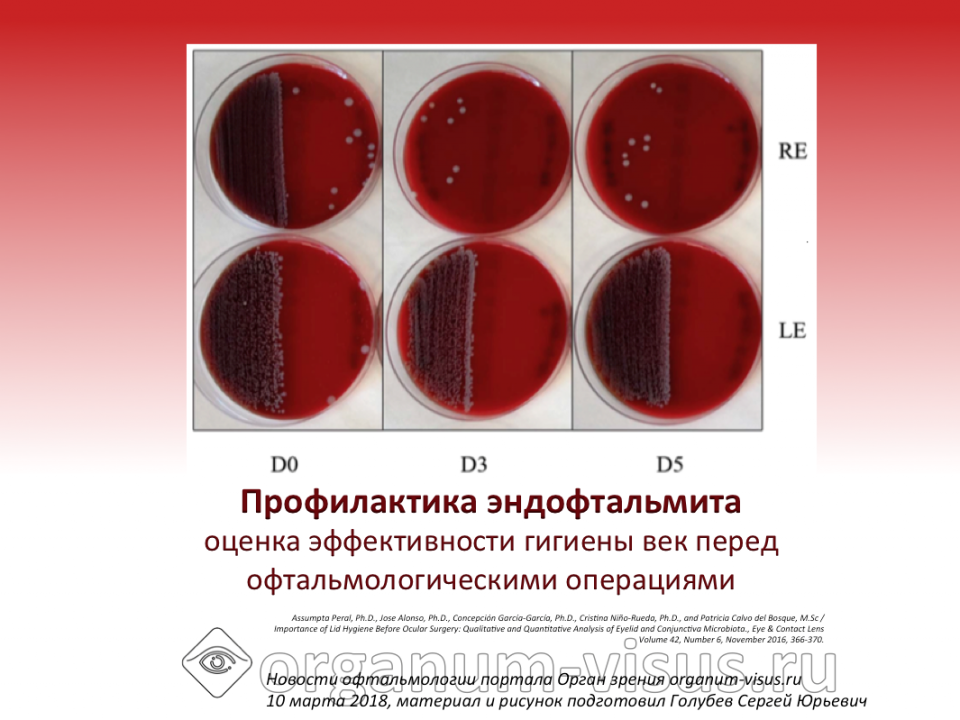
Профилактика эндофтальмита Блефаклин и глазная поверхность

Профилактика эндофтальмита. Блефаклин снижает обсемененность глазной поверхности.
Assumpta Peral с соавт. (Мадрид, Испания) оценили эффективность очищающей салфетки для век Блефаклин в снижении бактериальной обсемененности глазной поверхности перед хирургиеческой операцией.
Одноцентровое, проспективное, простое слепое фаза IV исследование 45 взрослых пациентов перед плановой операции катаракты. В течении 5 дней пациентов обследовали на 1-й, на 3-й день, и 5-й дни.
Салфетками Блефаклин пациенты обрабатывали тот глаз, на котором предстояла операция. Парный глаз не обрабатывали и считали контрольным.
На каждом визите авторы брали мазок с поверхности век и конъюнктивы. Выявленные бактерии идентифицировались.
Материал оценивали измеряя площадь питательной среды, покрытой выращенными колониями по отношению к общей доступной зоне.
На обработанных салфетками Блефаклин глазах на 3-й и 5-й дни снижение бактериальной обсемененности поверхности век составило 58% и 63% соответственно.
Отмечено снижение бактериальной обсемененности конъюнктивы: 72% и 69% на 3-й и 5-й день соответственно.
Авторы сделали выод, что степень снижения микробиоты сопоставима с полученными в других исследованиях результатами после местного применения антибиотиков .
Таким образом, салфетки для век Блефаклин целесообразно рекомендовать для гигиены век в качестве профилактики инфекционных осложнений перед любой офтальмологической операцией.
Источник: Assumpta Peral, Ph.D., Jose Alonso, Ph.D., Concepción García-García, Ph.D., Cristina Niño-Rueda, Ph.D., and Patricia Calvo del Bosque, M.Sc / Importance of Lid Hygiene Before Ocular Surgery: Qualitative and Quantitative Analysis of Eyelid and Conjunctiva Microbiota., Eye & Contact Lens Volume 42, Number 6, November 2016, 366-370.
Инфекция в офтальмологи. Инфекция в глазу. Дозированная травма. Послеоперационные осложнения. Endophthalmitis.



